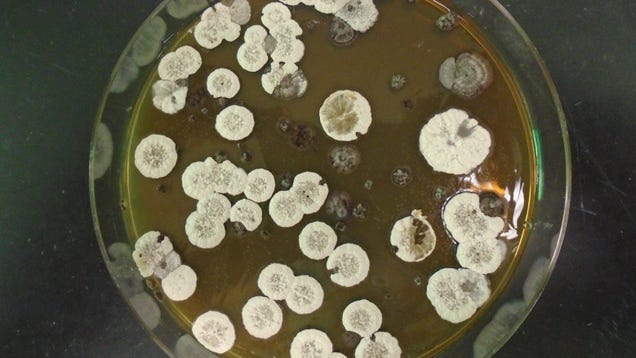

A popular rocket fuel called RP-1 gets its name from its key ingredient: refined petroleum. Research published last week in the journal Joule suggests a potentially cleaner and more powerful ingredient: a molecule produced by the Streptomyces bacteria. The proposed fuel won’t be ready any time soon, but the new…
Source: Gizmodo – Microbes May Hold the Secret to Creating More Powerful Rocket Fuel